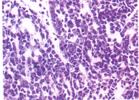
涎腺的未分化癌 涎腺的未分化癌

治療措施
涎腺未分化癌對放射治療有一定敏感性,但難以根治。目前多採用聯合治療的方法,如放療、根治性手術切除+化療等。手術多採用聯合根治術。
病理改變
鏡檢見癌細胞呈圓形或梭形,大小極不一致,形態不一,散在排列,呈極度異型性,核分裂象多見,並常見顯著的出血及壞死。
臨床表現
病程一般較短,腫瘤生長迅速,並呈浸潤性生長。患者早期即出現疼痛性腫塊。發生在腮腺者,早期即波及面神經出現癱瘓,與周圍組織粘連,腫塊固定。晚期皮膚受累可破潰,區域淋巴結轉移率較高,還可伴有遠處轉移,如轉移至肺、肝、骨等部位。
預後
涎腺未分化癌預後極差。由於此類型的腫瘤較少,國內外有關其生存率報告不多,Blank報告75例發生於腮腺的低分化癌5年生存率為32%,10年生存效率僅18%。